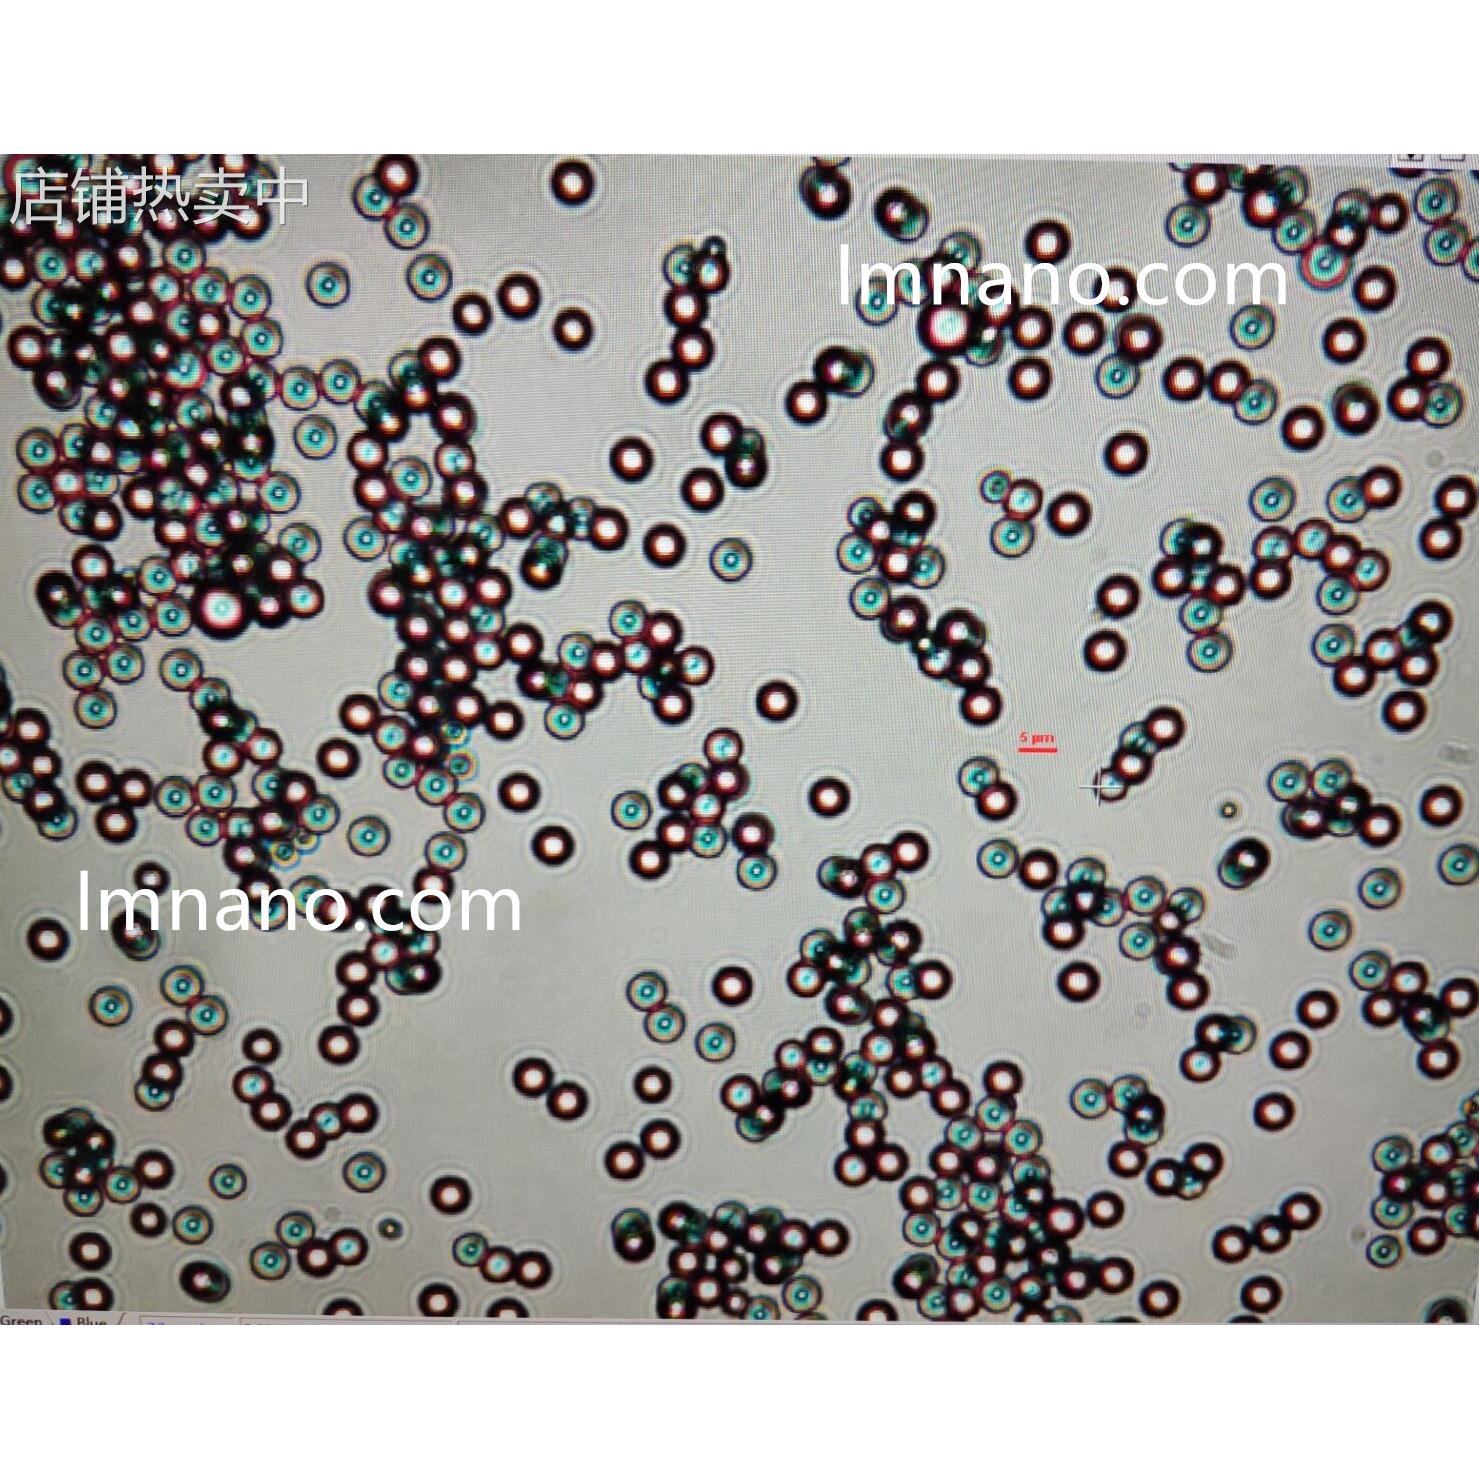
1um 蓝色乳胶微球

1um 优惠券折扣(5)
商品筛选
-
 模玩/动漫/周边/娃圈三坑/桌游
3380
券后价
模玩/动漫/周边/娃圈三坑/桌游
3380
券后价
3430方达 石墨密封环 平面研磨机 平面度≤1um 粗糙度纳米级研磨设备
淘宝好物 仰栋工厂直销
50元优惠券 -
 模玩/动漫/周边/娃圈三坑/桌游
6390
券后价
模玩/动漫/周边/娃圈三坑/桌游
6390
券后价
6470海德汉LS1378C/388C LS377C 70 120 170 220 270 320 370 1um现货
淘宝好物 乐购集商贸城的小店95
80元优惠券 -
 包装
879
券后价
包装
879
券后价
889板框式压滤机滤纸300*300精y度1um ~5um电厂过滤汽轮机油滤纸板
淘宝好物 好庆苑日用品
10元优惠券 -
 包装
879
券后价
包装
879
券后价
889板框式压滤机滤纸300*300精度1um ~5Kum电厂过滤汽轮机油滤纸板
淘宝好物 tb5621857414
10元优惠券 -
 包装
884
券后价
包装
884
券后价
894板框式压a滤机滤纸300*300精度1um ~5um电厂过滤汽轮机油滤纸板
淘宝好物 tb1684612974
10元优惠券 -
 五金/工具
92
券后价
五金/工具
92
券后价
93QXD不锈钢刮板细度计0-//100/1um细度板涂料大小颗粒细度仪
淘宝好物 盛创百货官营店
1元优惠券 -
 金属材料及制品
92.56
券后价
金属材料及制品
92.56
券后价
93.56高纯泡沫不锈钢 泡沫铁微米过滤级别实验耗材科研1um-um
淘宝好物 天阿粮油馆
1元优惠券 -
 金属材料及制品
92.56
券后价
金属材料及制品
92.56
券后价
93.56高纯泡沫不锈钢 泡沫铁微米过滤级别实验耗材科研专用1um-um
淘宝好物 盛创百货官营店19
1元优惠券 -
 橡塑材料及制品
2862
券后价
橡塑材料及制品
2862
券后价
28921um 蓝色乳胶微球
淘宝好物 宏泰 商贸
30元优惠券 -
橡塑材料及制品
2862
券后价
橡塑材料及制品
2862
券后价
28921um 蓝色乳胶微球
淘宝好物 恒飞五金商行
30元优惠券 -
 厨房电器
49.29
满件折
厨房电器
49.29
满件折
49.78滨特尔爱惠浦净水器PP棉滤芯10寸过滤器前置5UM/1UM折纸芯0.45UM
淘宝好物 tb56421318947
优惠0.49元 -
 宠物/宠物食品及用品
12.48
满件折
宠物/宠物食品及用品
12.48
满件折
12.6不锈钢粉末烧结滤芯 1um高精度微孔烧结片 316不锈钢粉末烧结板
淘宝好物 u[4066445229]
优惠0.12元 -
 五金/工具
1043
券后价
五金/工具
1043
券后价
1053精密套装针规白钢针规塞规针规通止规量规销式针规1um
淘宝好物 小兔乖乖德
10元优惠券 -
 床上用品
7294
券后价
床上用品
7294
券后价
7354包邮Millipore密理博聚四氟乙烯PTFE表面滤膜FALP04700/02500 1um
淘宝好物 老靳与瑞生
60元优惠券 -
 文具电教/文化用品/商务用品
650
券后价
文具电教/文化用品/商务用品
650
券后价
655精密618磨床光栅尺 0.5U1UM高精度分辨率 通用型光栅数显表
淘宝好物 水梅寺日用品的小店69
5元优惠券 -
 文具电教/文化用品/商务用品
651
券后价
文具电教/文化用品/商务用品
651
券后价
656精密618磨床光栅尺 0.5U1UM高精度分辨率 通用型光栅数显表
淘宝好物 飞兴坊日用品的小店3
5元优惠券 -
 金属材料及制品
658.5
券后价
金属材料及制品
658.5
券后价
663.5供应50nm铁粉 羟基铁粉 1um球形铁粉
淘宝好物 飞兴坊日用品的小店3
5元优惠券 -
 文具电教/文化用品/商务用品
768
券后价
文具电教/文化用品/商务用品
768
券后价
77324V电子尺 1UM高分辨率 PLC专用光栅尺 450MM超耐用光栅电子尺
淘宝好物 禄隆庄日用品的小店11
5元优惠券 -
 文具电教/文化用品/商务用品
480
券后价
文具电教/文化用品/商务用品
480
券后价
483长春七海光电 QH/200-200 1UM 5V 618磨床光栅尺防水防油江苏销售
淘宝好物 泥弥科技的小店14
3元优惠券 -
 文具电教/文化用品/商务用品
481
券后价
文具电教/文化用品/商务用品
481
券后价
484电子尺磨床光栅尺 QH/200-400 1UM 5V 618长春七海光电1U 高精度
淘宝好物 莲富商贸的小店36
3元优惠券 -
 文具电教/文化用品/商务用品
482
券后价
文具电教/文化用品/商务用品
482
券后价
485长春七海光电 QH/200-200 1UM 5V 618磨床光栅尺防水防油江苏销售
淘宝好物 轻榴五金的小店21
3元优惠券 -
 家装灯饰光源
1618.2
券后价
家装灯饰光源
1618.2
券后价
1628.2TAKEX竹中UM-TR50S1UM-TL50S1UM-T50S1
淘宝好物 销售63112
10元优惠券 -
 办公设备/耗材/相关服务
166.23
券后价
办公设备/耗材/相关服务
166.23
券后价
167.23whtmn1号定性滤纸滤膜1001-090/110/1/1/185/2 11um
淘宝好物 天河玩具店
1元优惠券 -
 文具电教/文化用品/商务用品
684
券后价
文具电教/文化用品/商务用品
684
券后价
687信和光栅尺KA-300 370 1UM 5V EAI-422数控液压伺服驱动位移反馈
淘宝好物 轻榴精品的小店7
3元优惠券 -
 电子元器件市场
2381.4
券后价
电子元器件市场
2381.4
券后价
2391.4赛多利斯15458-47-N聚醚砜滤膜孔径0.1um直径47mm/100片1盒
淘宝好物 销售67445
10元优惠券 -
 厨房电器
742
券后价
厨房电器
742
券后价
745新乡利尔多层不锈钢烧结片304/316L复合烧结滤网1um-300um 可定
淘宝好物 练荣百货的小店8
3元优惠券 -
 厨房电器
756
券后价
厨房电器
756
券后价
759新乡利尔多层不锈钢烧结片304/316L复合烧结滤网1um-300um 可定
淘宝好物 腻宇百货
3元优惠券 -
 标准件/零部件/工业耗材
2554
券后价
标准件/零部件/工业耗材
2554
券后价
2564单晶金刚石微粉 优惠供应金刚石单晶微粉1um 3um 5um 钻石粉
淘宝好物 贵庆轩日用品的小店94
10元优惠券 -
 模玩/动漫/周边/娃圈三坑/桌游
8080
券后价
模玩/动漫/周边/娃圈三坑/桌游
8080
券后价
8110高精度数显千分高度规1127-10F 薄膜测厚仪 12.5/1um 多种测力
淘宝好物 迈机百货店1
30元优惠券 -
 文具电教/文化用品/商务用品
815
券后价
文具电教/文化用品/商务用品
815
券后价
818光栅尺KA500-220 1UM TTL位移传感器精密仪器电子产品设备自动化
淘宝好物 基镜百货的小店79
3元优惠券